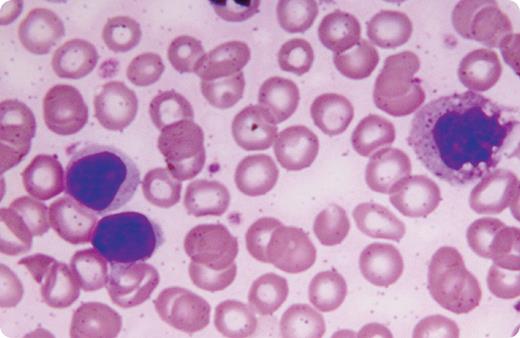
A 50-year-old female with low-grade chronic anemia and no other medical problems was evaluated when her hemoglobin fell to 8.2 g/dL. She had no adenopathy or hepatosplenomegaly. Her white cell count was 7.7 × 109/L with a lymphocyte count of 6.2 × 109/L, platelets 498 × 109/L, and reticulocyte count that was normal. Serum electrophoresis and rheumatoid factor were negative and ANA was weakly positive. Peripheral blood smear showed normocytic normochromic red cells and atypical large granular lymphocytes (see figure). Bone marrow examination showed prominence of lymphoid cells, most of which were granular. Aggregates of lymphocytes were noted that comprised approximately one-third of the nucleated cells. Special tests affirmed that these cells were of T-cell origin. A diagnosis of T-cell large granular lymphocyte leukemia was made. She was placed on chronic steroids because of the indolent nature of the disease. Two years later oral weekly methotrexate was added because of symptomatic progression manifested by worsening anemia (hemoglobin 6.3 g/dL). Subsequently, she died of complications after an episode of acute cholecystitis. / T-cell large granular lymphocyte leukemia is a chronic disorder often treated by observation only. When evidence of progression occurs, immunosuppressive medications are usually tried. The disease can also be associated with other immunologic disorders.

A 50-year-old female with low-grade chronic anemia and no other medical problems was evaluated when her hemoglobin fell to 8.2 g/dL. She had no adenopathy or hepatosplenomegaly. Her white cell count was 7.7 × 109/L with a lymphocyte count of 6.2 × 109/L, platelets 498 × 109/L, and reticulocyte count that was normal. Serum electrophoresis and rheumatoid factor were negative and ANA was weakly positive. Peripheral blood smear showed normocytic normochromic red cells and atypical large granular lymphocytes (see figure). Bone marrow examination showed prominence of lymphoid cells, most of which were granular. Aggregates of lymphocytes were noted that comprised approximately one-third of the nucleated cells. Special tests affirmed that these cells were of T-cell origin. A diagnosis of T-cell large granular lymphocyte leukemia was made. She was placed on chronic steroids because of the indolent nature of the disease. Two years later oral weekly methotrexate was added because of symptomatic progression manifested by worsening anemia (hemoglobin 6.3 g/dL). Subsequently, she died of complications after an episode of acute cholecystitis.
T-cell large granular lymphocyte leukemia is a chronic disorder often treated by observation only. When evidence of progression occurs, immunosuppressive medications are usually tried. The disease can also be associated with other immunologic disorders.
A 50-year-old female with low-grade chronic anemia and no other medical problems was evaluated when her hemoglobin fell to 8.2 g/dL. She had no adenopathy or hepatosplenomegaly. Her white cell count was 7.7 × 109/L with a lymphocyte count of 6.2 × 109/L, platelets 498 × 109/L, and reticulocyte count that was normal. Serum electrophoresis and rheumatoid factor were negative and ANA was weakly positive. Peripheral blood smear showed normocytic normochromic red cells and atypical large granular lymphocytes (see figure). Bone marrow examination showed prominence of lymphoid cells, most of which were granular. Aggregates of lymphocytes were noted that comprised approximately one-third of the nucleated cells. Special tests affirmed that these cells were of T-cell origin. A diagnosis of T-cell large granular lymphocyte leukemia was made. She was placed on chronic steroids because of the indolent nature of the disease. Two years later oral weekly methotrexate was added because of symptomatic progression manifested by worsening anemia (hemoglobin 6.3 g/dL). Subsequently, she died of complications after an episode of acute cholecystitis.
T-cell large granular lymphocyte leukemia is a chronic disorder often treated by observation only. When evidence of progression occurs, immunosuppressive medications are usually tried. The disease can also be associated with other immunologic disorders.
For additional images, visit the ASH IMAGE BANK, a reference and teaching tool that is continually updated with new atlas and case study images. For more information visit http://imagebank.hematology.org.